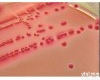
瓶、袋、箱、盒 嗜热<em>脂肪肝</em>菌恢复琼脂培养基

产品信息
核磁小鼠脂肪肝分析
:
MesoQMR清醒小动物体成分分析仪适用于测量活体小鼠、大鼠及其他小动物体内全组分的台式核磁共振分析仪,可快速、无损准确的测量大、小鼠脂肪、水分、瘦肉含量。MesoQMR清醒小动物体成分分析仪(动物脂肪/代谢测量仪),是基于核磁共振(NMR)原理的分析技术。不同组织中H质子含量以及H质子的弛豫时间均有一定的差异,可通过核磁共振信号强度与弛豫时间差异,用特定的信号处理与算法将脂肪、水分、瘦肉含量快速的区分开来。该方法可在小动物清醒状态下完成测试,测试过程对动物没有伤害,可对同一动物模型进行长期持续研究,排除个体差异影响。该仪器可用于从事糖尿病、肥胖症、代谢研究和营养学的科研机构、相应的大学和制药公司。
技术指标:
1、磁体类型:永磁体;
2、磁场强度:0.5±0.08T,仪器主频率:21.3MHz;
3、探头线圈直径:60mm;应用解决方案:
1、肥胖研究
2、糖尿病
3、营养学研究
4、药理学
5、骨质疏松症
6、心脏病学等研究
仪器优势与功能:
1、脂肪含量测定
2、瘦肉含量测定
3、自由水含量测定
4、几分钟内检测全身的肌肉、脂肪和水分含量
5、适合不同体位的测试,放样对测试无影响
6、永磁体,无维护费用,使用成本低
7、适用于裸鼠、小鼠和大鼠
8、测试过程无损伤,对动物无风险
9、动物可在清醒状态下测试,无需麻醉,测试过程简单
应用案例一:快速测定老鼠脂肪,瘦肉含量
测试应用软件
注:仪器外观如有变动,以产品技术资料为准。
核磁小鼠脂肪肝分析